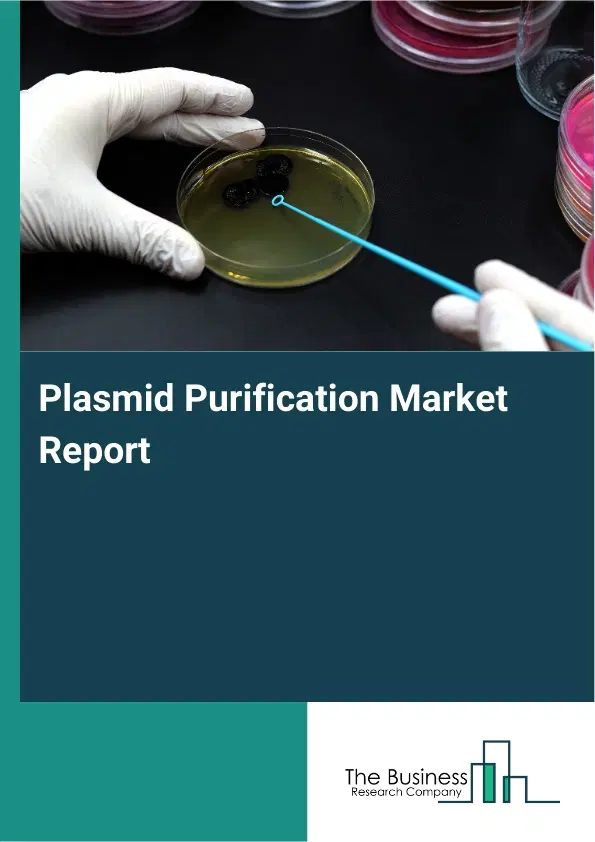
Global Plasmid Purification Market Report 2026

Plasmid Purification Market Report 2026
Global Outlook – By Product Type (Mini Plasmid Purification Kits, Midi Plasmid Purification Kits, Maxi Plasmid Purification Kits, Reagents And Consumables, Instruments And Systems, Other Product Types), By Technology (Alkaline Lysis Method, Spin Column Method, Magnetic Bead-Based Method, Filter-Based Method), By Application (Genetic Engineering, Cloning, Transfection, Vaccines Development), By End-User (Academic Research Institutions, Pharmaceutical Companies, Biotechnology Firms, Contract Research Organizations (CROs)) – Market Size, Trends, Strategies, and Forecast to 2035
Plasmid Purification Market Overview
• Plasmid Purification market size has reached to $2.26 billion in 2025 • Expected to grow to $4.44 billion in 2030 at a compound annual growth rate (CAGR) of 14.4% • Growth Driver: Increasing Demand For Gene Therapies Fueling The Growth Of The Market Due To Advancements In Genetic Sequencing And Targeted Treatments • Market Trend: Innovative Purification Technology Reduces Contamination Risks • North America was the largest region in 2025 and Asia-Pacific is the fastest growing region.What Is Covered Under Plasmid Purification Market?
Plasmid purification is the process of isolating plasmid DNA from bacterial cells while removing proteins, RNA, and other cellular components. It is used to obtain high-purity plasmid DNA suitable for downstream applications in molecular biology research. It ensures that the DNA is intact, contaminant-free, and functional for experimental use. The main product types of plasmid purification are mini plasmid purification kits, midi plasmid purification kits, maxi plasmid purification kits, reagents and consumables, instruments and systems, and others. Mini plasmid purification kits are designed for the rapid isolation of small quantities of plasmid DNA, typically from bacterial cultures of 1-5 ml. These utilize various technologies such as the alkaline lysis method, spin column method, magnetic bead-based method, and filter-based method. It finds applications in genetic engineering, cloning, transfection, and vaccine development, serving end users such as academic research institutions, pharmaceutical companies, biotechnology firms, and contract research organizations (CROs).
What Is The Plasmid Purification Market Size and Share 2026?
The plasmid purification market size has grown rapidly in recent years. It will grow from $2.26 billion in 2025 to $2.59 billion in 2026 at a compound annual growth rate (CAGR) of 14.6%. The growth in the historic period can be attributed to limited availability of purification kits, reliance on manual plasmid isolation methods, growth of molecular biology research, increasing academic research funding, adoption of standard genetic engineering protocols.What Is The Plasmid Purification Market Growth Forecast?
The plasmid purification market size is expected to see rapid growth in the next few years. It will grow to $4.44 billion in 2030 at a compound annual growth rate (CAGR) of 14.4%. The growth in the forecast period can be attributed to development of automated high-throughput purification systems, rising demand for large-scale plasmid production, growth in vaccine and gene therapy applications, increasing collaboration between biotech and pharmaceutical companies, integration of magnetic bead and advanced filtration technologies. Major trends in the forecast period include rising demand for high-purity plasmid dna in molecular biology research, adoption of automated purification systems and high-throughput technologies, expansion of vaccine development and genetic engineering applications, increasing use of magnetic bead and spin column-based purification kits, growing investment in academic and pharmaceutical research programs.Global Plasmid Purification Market Segmentation
1) By Product Type: Mini Plasmid Purification Kits, Midi Plasmid Purification Kits, Maxi Plasmid Purification Kits, Reagents And Consumables, Instruments And Systems, Other Product Types 2) By Technology: Alkaline Lysis Method, Spin Column Method, Magnetic Bead-Based Method, Filter-Based Method 3) By Application: Genetic Engineering, Cloning, Transfection, Vaccines Development 4) By End-User: Academic Research Institutions, Pharmaceutical Companies, Biotechnology Firms, Contract Research Organizations (CROs) Subsegments: 1) By Mini Plasmid Purification Kits: Spin Column Kits, Magnetic Bead Kits, Filter Plate Kits, Manual Kit Systems 2) By Midi Plasmid Purification Kits: Spin Column Kits, Gravity Flow Kits, Vacuum Filtration Kits, Automated Midi Kits 3) By Maxi Plasmid Purification Kits: Gravity Flow Kits, Vacuum Filtration Kits, Large-Scale Automated Kits, Membrane Adsorption Kits 4) By Reagents And Consumables: Buffers, Enzymes, Solutions, Columns, Membranes 5) By Instruments And Systems: Automated Purification Systems, Centrifuges, Magnetic Separators, Filtration Devices 6) By Other Product Types: Kits For Endotoxin Removal, Kits For Ribonucleic Acid (RNA) Removal, Kits For Genomic Deoxyribonucleic Acid (DNA) Removal, Accessories And OthersWhat Is The Driver Of The Plasmid Purification Market?
The increasing demand for gene therapies is expected to propel the growth of the plasmid purification market going forward. Gene therapy refers to a medical technique that involves modifying or replacing defective genes to treat or prevent diseases. The increasing demand for gene therapy is due to advancements in genetic sequencing and diagnostics, which enable precise identification of disease-causing genes for targeted treatment. Plasmid purification enhances gene therapy development by providing high-quality, pure plasmid DNA, making it essential for efficient and safe therapeutic applications. It reduces production bottlenecks by enabling scalable and reproducible plasmid isolation, improving research and biomanufacturing outcomes. For instance, in December 2024, according to the American Society of Gene & Cell Therapy (ASGCT), a US-based non-profit medical and scientific organization, the Food and Drug Administration (FDA) approved six gene therapy products in 2023, up from five approvals in 2022. Therefore, the increasing demand for gene therapies is driving the growth of the plasmid purification industry.Key Players In The Global Plasmid Purification Market
Major companies operating in the plasmid purification market are Thermo Fisher Scientific Inc., Merck KGaA, Bio-Rad Laboratories Inc., Qiagen N.V., GenScript Biotech Corporation, Takara Bio Inc., Promega Corporation, Aldevron LLC, New England Biolabs Inc., Origene Technologies Inc., Applied Biological Materials, InvivoGen, Omega Bio-tek Inc., ABP Biosciences, Zymo Research Corporation, Oxford Genetics Ltd., Norgen Biotek Corp., PlasmidFactory GmbH & Co. KG.Global Plasmid Purification Market Trends and Insights
Major companies operating in the plasmid purification market are focusing on developing technologically advanced products, such as the automated plasmid maxi-prep purification system, to enhance efficiency, improve yield, and ensure higher purity of plasmid DNA. An automated plasmid maxi-prep purification system refers to a technology that automatically isolates large amounts of high-purity plasmid DNA from bacterial cultures, streamlining the purification process for increased efficiency and consistency. For instance, in June 2023, GenScript Biotech Corporation, a US-based biotechnology company, launched the AmMag Quatro, an advanced, fully automated high-throughput plasmid maxi-prep purification system. This scalable and modular platform can simultaneously operate up to four independent purification modules, processing a total of 24 samples in about two hours. AmMag Quatro leverages magnetic silica bead technology to deliver high-quality, transfection-grade plasmid DNA with low endotoxin levels and a high supercoiled DNA ratio, ensuring ready-to-use plasmids for downstream applications. Its innovative design ensures high reproducibility, reduces contamination risks, and significantly increases processing capacity, making it ideal for large-scale research and bioproduction applications.What Are Latest Mergers And Acquisitions In The Plasmid Purification Market?
In July 2023, Sartorius AG, a Germany-based biotechnology company, acquired Polyplus SAS for an undisclosed amount. With this acquisition, Sartorius aims to strengthen its upstream capabilities in cell and gene therapy manufacturing by integrating plasmid DNA supply and transfection reagent technologies into its portfolio. Polyplus SAS is a France-based biotechnology company specializing in plasmid DNA purification solutions.Regional Insights
North America was the largest region in the plasmid purification market in 2025. Asia-Pacific is expected to be the fastest-growing region in the forecast period. The regions covered in this market report are Asia-Pacific, South East Asia, Western Europe, Eastern Europe, North America, South America, Middle East, Africa. The countries covered in this market report are Australia, Brazil, China, France, Germany, India, Indonesia, Japan, Taiwan, Russia, South Korea, UK, USA, Canada, Italy, Spain.What Defines the Plasmid Purification Market?
The plasmid purification market consists of revenues earned by entities by providing services such as plasmid isolation, extraction, quality testing, custom plasmid preparation, and analytical support for research and industrial applications. The market value includes the value of related goods sold by the service provider or included within the service offering. The plasmid purification market also includes sales of buffers, enzymes, endotoxin removal resins, plasmid extraction columns, nucleic acid binding membranes, and automated plasmid purification systems. Values in this market are ‘factory gate’ values, that is the value of goods sold by the manufacturers or creators of the goods, whether to other entities (including downstream manufacturers, wholesalers, distributors and retailers) or directly to end customers. The value of goods in this market includes related services sold by the creators of the goods.How is Market Value Defined and Measured?
The market value is defined as the revenues that enterprises gain from the sale of goods and/or services within the specified market and geography through sales, grants, or donations in terms of the currency (in USD unless otherwise specified). The revenues for a specified geography are consumption values that are revenues generated by organizations in the specified geography within the market, irrespective of where they are produced. It does not include revenues from resales along the supply chain, either further along the supply chain or as part of other products.What Key Data and Analysis Are Included in the Plasmid Purification Market Report 2026?
The plasmid purification market research report is one of a series of new reports from The Business Research Company that provides market statistics, including industry global market size, regional shares, competitors with the market share, detailed market segments, market trends and opportunities, and any further data you may need to thrive in the plasmid purification industry. The market research report delivers a complete perspective of everything you need, with an in-depth analysis of the current and future state of the industry.Plasmid Purification Market Report Forecast Analysis
| Report Attribute | Details |
|---|---|
| Market Size Value In 2026 | $2.59 billion |
| Revenue Forecast In 2035 | $4.44 billion |
| Growth Rate | CAGR of 14.6% from 2026 to 2035 |
| Base Year For Estimation | 2025 |
| Actual Estimates/Historical Data | 2020-2025 |
| Forecast Period | 2026 - 2030 - 2035 |
| Market Representation | Revenue in USD Billion and CAGR from 2026 to 2035 |
| Segments Covered | Product Type, Technology, Application, End-User |
| Regional Scope | Asia-Pacific, Western Europe, Eastern Europe, North America, South America, Middle East, Africa |
| Country Scope | The countries covered in the report are Australia, Brazil, China, France, Germany, India, ... |
| Key Companies Profiled | Thermo Fisher Scientific Inc., Merck KGaA, Bio-Rad Laboratories Inc., Qiagen N.V., GenScript Biotech Corporation, Takara Bio Inc., Promega Corporation, Aldevron LLC, New England Biolabs Inc., Origene Technologies Inc., Applied Biological Materials, InvivoGen, Omega Bio-tek Inc., ABP Biosciences, Zymo Research Corporation, Oxford Genetics Ltd., Norgen Biotek Corp., PlasmidFactory GmbH & Co. KG. |
| Customization Scope | Request for Customization |
| Pricing And Purchase Options | Explore Purchase Options |